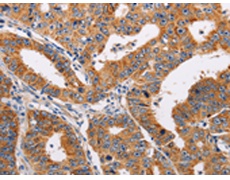
一抗

中文名稱: 兔抗ADH1A多克隆抗體
|
Background: |
This gene encodes a member of the alcohol dehydrogenase family. The encoded protein is the alpha subunit of class I alcohol dehydrogenase, which consists of several homo- and heterodimers of alpha, beta and gamma subunits. Alcohol dehydrogenases catalyze the oxidation of alcohols to aldehydes. This gene is active in the liver in early fetal life but only weakly active in adult liver. This gene is found in a cluster with six additional alcohol dehydrogenase genes, including those encoding the beta and gamma subunits, on the long arm of chromosome 4. Mutations in this gene may contribute to variation in certain personality traits and substance dependence. |
|
Applications: |
ELISA, IHC |
|
Name of antibody: |
ADH1A |
|
Immunogen: |
Fusion protein of human ADH1A |
|
Full name: |
alcohol dehydrogenase 1A (class I), alpha polypeptide |
|
Synonyms: |
ADH1 |
|
SwissProt: |
P07327 |
|
IHC positive control: |
Human gastric cancer and human thyroid cancer |
|
IHC Recommend dilution: |
25-100 |

 購物車
購物車 幫助
幫助
 021-54845833/15800441009
021-54845833/15800441009